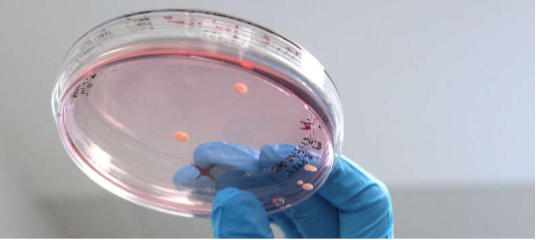

2023-04-13
来源: drugdu
319

研究精神疾病的生物学基础极其困难,部分原因是研究人员无法轻易地从活人身上收集脑细胞进行实验室研究。现在,犹他大学的健康科学家们已经开发出了一种解决这一问题的方法。
研究人员从一名儿童双相情感障碍患者和几名家庭成员捐赠的血细胞中培育出被称为“类器官”的三维结构。该方法确定了与精神疾病相关的重大分子变化。
这项发表在《分子精神病学》上的研究结果表明,儿童双相情感障碍患者大脑的结构变化可能是由一种有助于细胞信号传导的基因功能障碍引起的。研究结果还表明,实验室培养的类器官可以深入了解精神疾病的病因。
犹他大学神经生物学助理教授、该研究的高级作者alex shcheglovitov博士说:“如果我们没有动物模型,就无法在临床前研究中寻找治疗方法。这是一个巨大的挑战。”。研究生杨光是这篇论文的第一作者。“肯定有必要开发新的创新模型来研究儿童双相情感障碍的细胞和分子机制。”
双极性脑的变化
双相情感障碍是一种导致极度情绪波动的精神疾病,在抑郁和躁狂之间波动。当这种疾病发生在儿童时期时,这可能是一个与强大的遗传成分有关的迹象。shcheglovitov及其同事认为,这种复杂的疾病需要一种创新的、多学科的方法来研究。
该论文的合著者、精神病学家melissa lopez-larson医学博士对患有儿童双相情感障碍的儿童及其未受影响的家庭成员进行了脑成像,以观察该疾病如何改变大脑区域之间的联系。在双相情感障碍患者中,一种名为功能性mri(fmri)的成像技术可以揭示大脑静息活动的变化,尽管尚不清楚是什么导致了这些变化。
为了了解更多信息,lopez-larson与神经生物学家shcheglovitov和yang,以及美国大学卫生和亨茨曼精神健康研究所的放射科医生、遗传学家和精神病学家合作,将成像数据与分子水平的患者细胞深入分析相结合。
yang的研究从一名患有双相情感障碍的9岁男孩、他的父母和一个未受影响的兄弟姐妹捐献的血细胞开始。通过在适当的条件下培养细胞,yang诱导它们成为干细胞,然后将干细胞生长为神经元。然后,使用shcheglovitov小组最近开发的一种方法,将细胞转化为称为类器官的结构化簇。类器官模仿了人类大脑发育的早期阶段,使研究人员能够研究神经元之间的交流,类似于活体大脑中发生的相互作用。
shcheglovitov说:“这些类器官使我们能够对与某些大脑区域相关的某些发育阶段进行建模。”。“在我们的案例中,类器官更像胎儿大脑的前部。”
寻找原因
为了找到这种疾病的根本原因,yang进行了测试,以确定患有双相情感障碍的儿童的细胞与他的家庭成员有何不同。“yang发现患者的一种名为plxnb1的基因发生了变化,该基因以前与精神疾病有关。他还发现细胞看起来不同:被称为“神经炎”的神经元过程更短。这些长卷须通常与相邻细胞建立重要联系。
将正常的plxnb1添加到患者的细胞中可以使轴突生长到正常大小,证实plxnb2的突变导致了轴突生长的变化。“这太令人兴奋了,”shcheglovitov说。“这表明,使用基于基因的治疗,或另一种靶向plxnb1通路的治疗,可能与儿童双相情感障碍患者的治疗相关。”
在研究结果能够带来新的治疗方法之前,研究人员需要进行更大规模的研究,以确定其他患有这种疾病的人是否有相同的差异。lopez-larson说,这项研究的力量在于将多种技术结合起来,创造出一幅关于大脑中发生的事情的清晰画面。
lopez-larson说:“功能磁共振成像显示,大脑连接是非典型的,至少在这个特定的孩子身上是这样。我们还发现,基因片段也是一样的。”。“我们能够使用不同种类的先进技术,以不同的方式揭示相同的东西。”
期刊信息来源:分子精神病学
责编: editor您已成功订阅,无需重复提交。
确认
请输入正确邮箱!
订阅
邮件订阅热门医贸资讯,了解第一手信息。